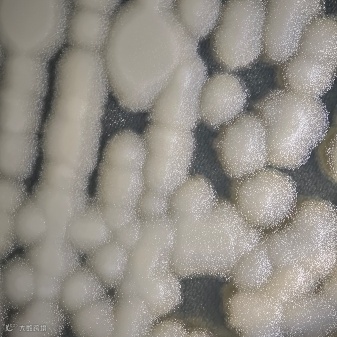
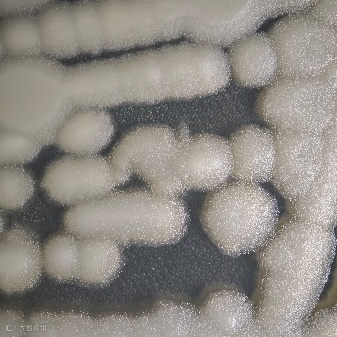
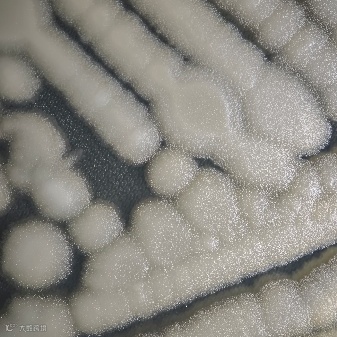
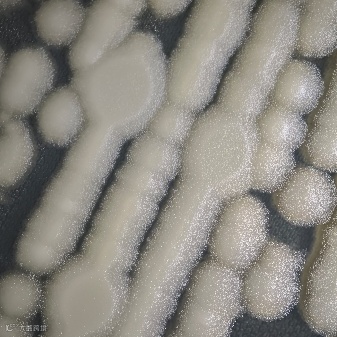
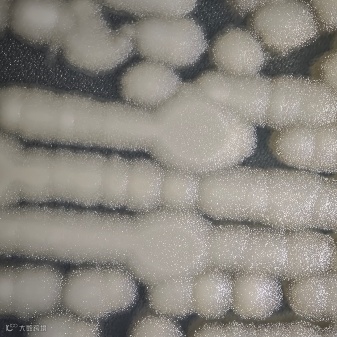
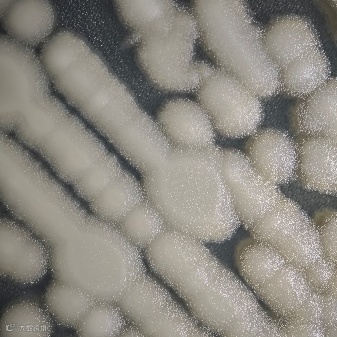
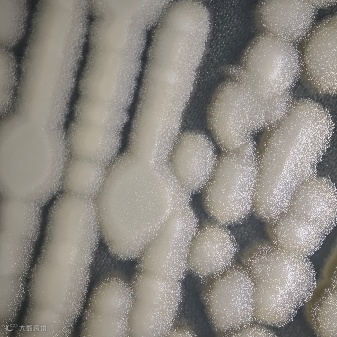
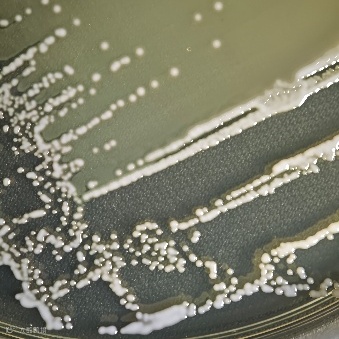
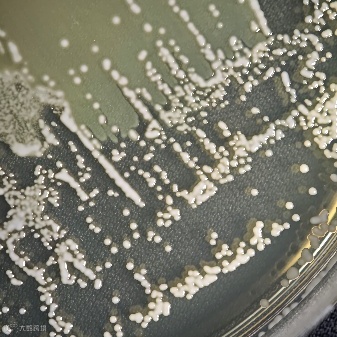
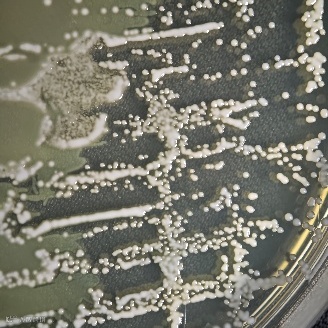
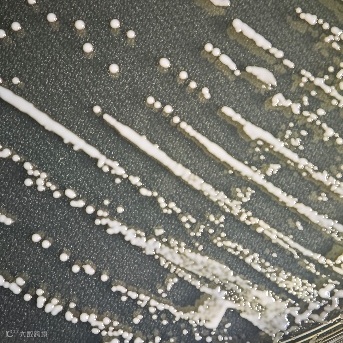
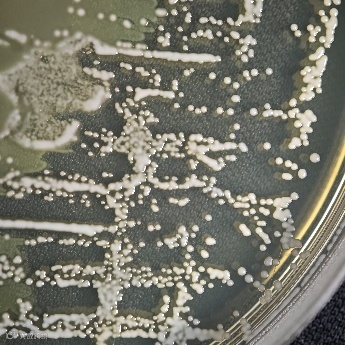
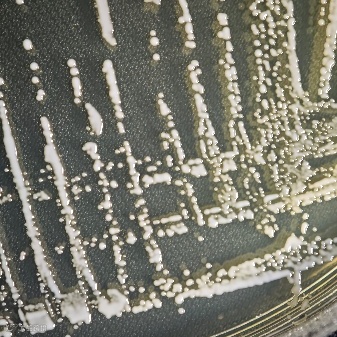
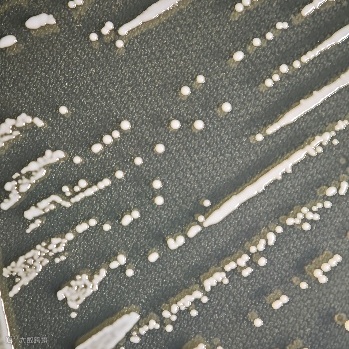
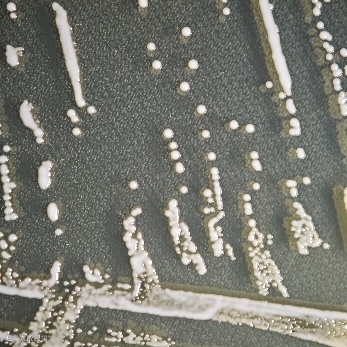
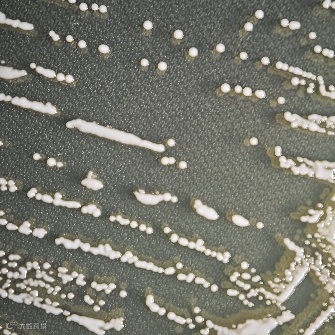
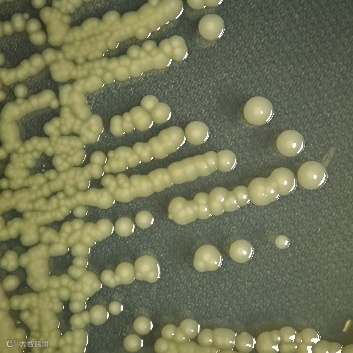
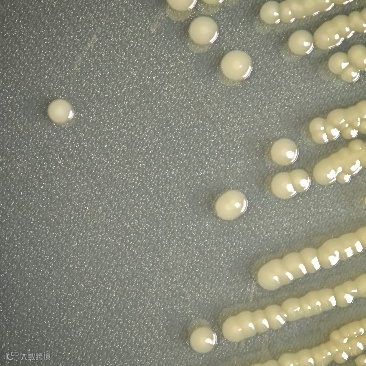
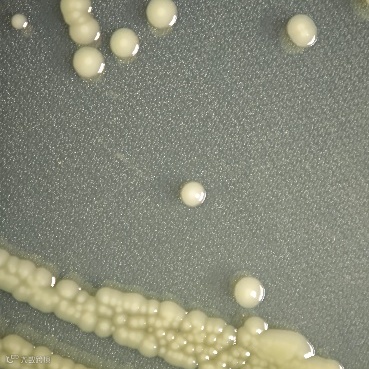
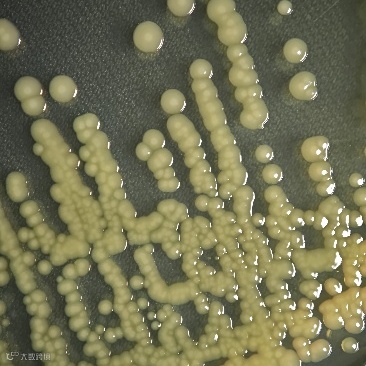
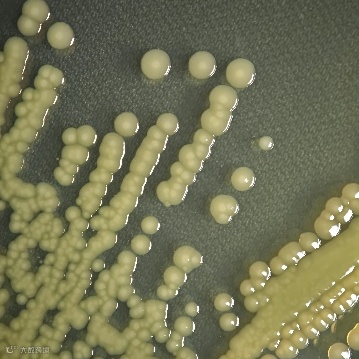
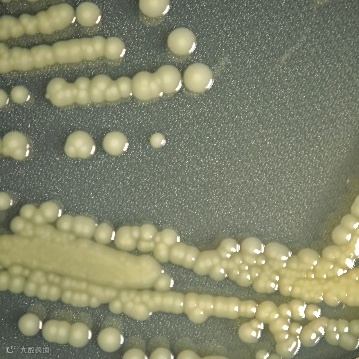
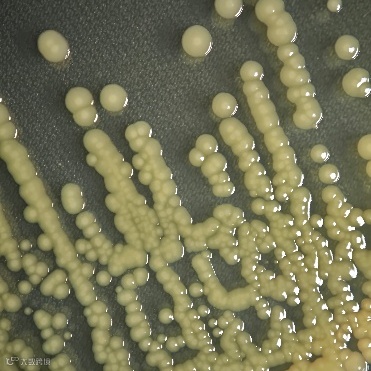
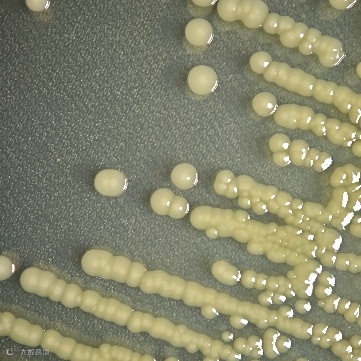
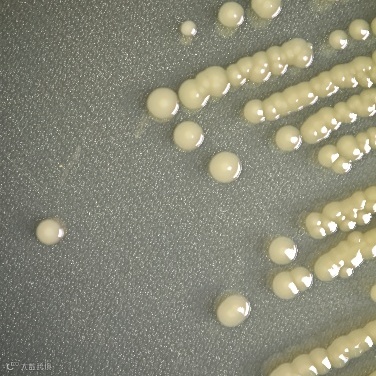

点击蓝字 关注我们
蜡样芽孢杆菌 Bacillus cereus









头葡萄球菌









考氏肠杆菌 Enterobacter cowanii









 惠世咨询
惠世咨询点击蓝字 关注我们
蜡样芽孢杆菌 Bacillus cereus

头葡萄球菌

考氏肠杆菌 Enterobacter cowanii